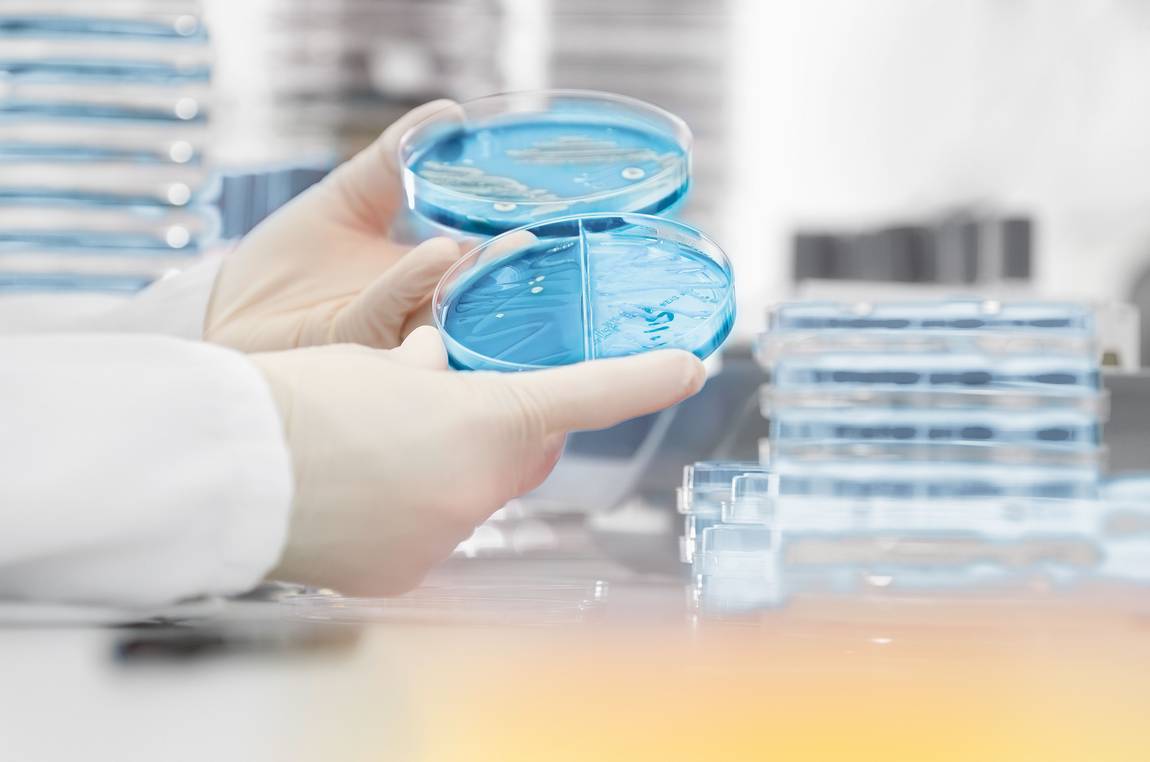

Durch konsequente Anwendung aller Regelwerke und durch Einhaltung aller geltenden Qualitätskriterien können wir innerhalb kürzester Zeit Infektionen nachweisen und damit einen wesentlichen Beitrag zur Diagnose und Therapie leisten.
Die ständige telefonische Erreichbarkeit unserer Mitarbeiter sichert die sofortige und zuverlässige fachliche Beantwortung aller infektiologischen Fragen.